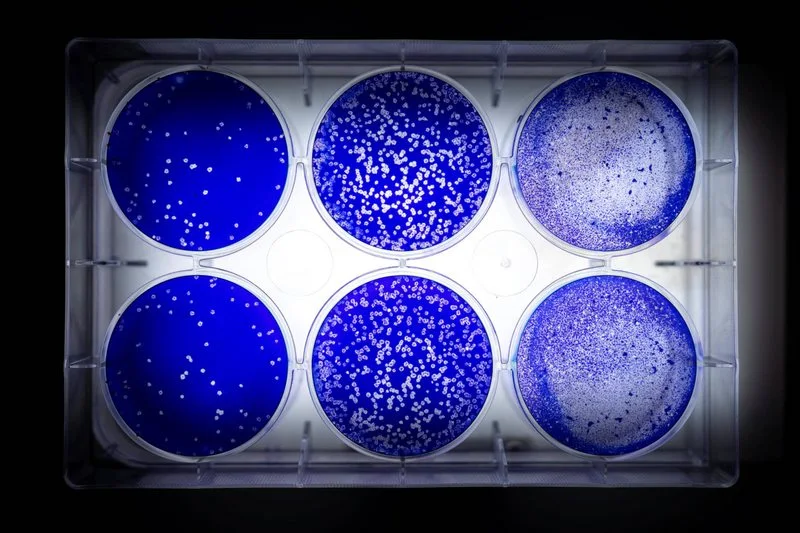

Una de las características del SARS COV-2, el virus que provoca la enfermedad
Covid-19, es que muta constantemente. Y son precisamente esas variaciones las
que quiere pesquisar el Consorcio Genomas COV2, un grupo de científicos chilenos,
coordinados por el Ministerio de Ciencia, que desarrolló la plataforma Cov2.cl.
Miguel Allende, doctor en Biología Molecular y director del Centro de Regulación del Genoma, lidera esta base de datos donde se analizan las muestras del material genético del virus. "El coronavirus tiene una secuencia de ARN (ácido ribonucleico) de aproximadamente 30 mil nucleótidos de longitud y consta de cuatro proteínas estructurales. Cuando cambia uno de esos 30 mil o una de las proteínas, se produce una variante o mutación. La idea de la plataforma es que sea un repositorio o una colección de todas las secuencias de los genomas del SARS COV-2 que se están obteniendo en Chile para poder compararlas en término de sus variaciones tanto entre ellas como entre las secuencias del resto del mundo", dice Allende.
Hasta el momento, la plataforma ha analizado 157 secuencias o muestras del genoma del virus, una proporción bastante alta comparada con Sudamérica, donde se han realizado 345 análisis. "De esas secuencias, el número de variaciones en Chile está en 598 hasta ahora. Este virus cambia bastante rápido en el tiempo", explica el doctor en Biología Molecular.
Cuando uno toma las variantes y las compara entre ellas se pueden hacer relaciones filogenéticas, una especie de árbol genealógico que las relaciona para ver su distribución: "Nuestro árbol lo podemos comparar con el árbol mundial, porque los genomas de todos los países está siendo depositados en la bases de datos pública, GISAID. En el mundo ya hay más de 30 mil secuencias que se pueden comparar".
-¿Por qué es importante conocer estas mutaciones?
-Las variaciones permiten trazar el origen, como se está comportando esa variante en la población y cómo se está distribuyendo. Cuando hayan brotes nuevos, una vez superado lo que estamos pasando ahora, vamos a poder saber de dónde salió ese brote. Si fue una persona que llegó del exterior, si estaba acá, etcétera.
-¿De qué depende que vayan saliendo variantes nuevas?
-Surge naturalmente en el proceso de vida del virus. Los genomas distintos pueden generar distintos resultados en términos del comportamiento del virus. Podría ser distinto en términos de sus características. Hay algunos reportes que han hablado de eso, de que podría aparecer un virus más virulento o resistente, pero no hay ninguna evidencia de que eso haya pasado aún. Es importante monitorearlas. A eso se le llama vigilancia genómica.
-¿De las 598 variantes reportadas en Chile, cuáles son las más comunes?
-Si uno toma todas las secuencias virales y les busca parentesco uno puede hacer grupos. Las más comunes en Chile son las del grupo A, en donde están la Al y la A2a, y el grupo B, donde están B y la BI. De esas, la más presente es la A2a.
-¿En qué se diferencian?
-Las del grupo B son más cercanas a las secuencias chinas. Las del A probablemente pasaron por otras partes del mundo, más cerca de Europa. Si bien son diferentes en su genoma no se ha encontrado ninguna diferencia en la capacidad infectiva ni en el grado de severidad de la enfermedad. La variante A2a es también una de las más frecuente en todo el mundo. Esa se caracteriza por tener una mutación en la proteína Spike. Esa variante se originó probablemente después que el virus salió de Asia.
-¿Cómo están distribuidas estas mutaciones en Chile?
-Están bien distribuidas por todos lados, porque al comienzo la gente viajó a distintas regiones. No hay una variante que se restringa a un solo lugar. De las muestras que tenemos se puede concluir hasta ahora que tenemos secuencias más parecidas a las europeas.
Fernando Valiente, académico del Programa de Virología de la Universidad de Chile, aplaude esta plataforma. "Me parece maravilloso tener este mapa. Permite mantener una vigilancia constante de las variantes del virus que circulan Chile y eso nos permite conocer la evolución del virus, cuál es el origen. Eso, a su vez, repercute en ver cuáles son las características, si va cambiando en el tiempo en las diferentes poblaciones que va infectando. Eso es importante porque si va cambiando, puede repercutir en los métodos de diagnóstico que estamos utilizando. Nosotros tenemos un método de diagnóstico molecular que se basa en la secuencia genómica del virus y si este cambia, lo más seguro es que tengamos que precisar las sondas que se utilizan para hacer el diagnóstico. Sabemos a priori que la tendencia mundial dice que no cambia mucho y por lo mismo no se puede hablar de distintas cepas, sino de variantes".
Miguel Allende, doctor en Biología Molecular y director del Centro de Regulación del Genoma, lidera esta base de datos donde se analizan las muestras del material genético del virus. "El coronavirus tiene una secuencia de ARN (ácido ribonucleico) de aproximadamente 30 mil nucleótidos de longitud y consta de cuatro proteínas estructurales. Cuando cambia uno de esos 30 mil o una de las proteínas, se produce una variante o mutación. La idea de la plataforma es que sea un repositorio o una colección de todas las secuencias de los genomas del SARS COV-2 que se están obteniendo en Chile para poder compararlas en término de sus variaciones tanto entre ellas como entre las secuencias del resto del mundo", dice Allende.
Hasta el momento, la plataforma ha analizado 157 secuencias o muestras del genoma del virus, una proporción bastante alta comparada con Sudamérica, donde se han realizado 345 análisis. "De esas secuencias, el número de variaciones en Chile está en 598 hasta ahora. Este virus cambia bastante rápido en el tiempo", explica el doctor en Biología Molecular.
Cuando uno toma las variantes y las compara entre ellas se pueden hacer relaciones filogenéticas, una especie de árbol genealógico que las relaciona para ver su distribución: "Nuestro árbol lo podemos comparar con el árbol mundial, porque los genomas de todos los países está siendo depositados en la bases de datos pública, GISAID. En el mundo ya hay más de 30 mil secuencias que se pueden comparar".
-¿Por qué es importante conocer estas mutaciones?
-Las variaciones permiten trazar el origen, como se está comportando esa variante en la población y cómo se está distribuyendo. Cuando hayan brotes nuevos, una vez superado lo que estamos pasando ahora, vamos a poder saber de dónde salió ese brote. Si fue una persona que llegó del exterior, si estaba acá, etcétera.
-¿De qué depende que vayan saliendo variantes nuevas?
-Surge naturalmente en el proceso de vida del virus. Los genomas distintos pueden generar distintos resultados en términos del comportamiento del virus. Podría ser distinto en términos de sus características. Hay algunos reportes que han hablado de eso, de que podría aparecer un virus más virulento o resistente, pero no hay ninguna evidencia de que eso haya pasado aún. Es importante monitorearlas. A eso se le llama vigilancia genómica.
-¿De las 598 variantes reportadas en Chile, cuáles son las más comunes?
-Si uno toma todas las secuencias virales y les busca parentesco uno puede hacer grupos. Las más comunes en Chile son las del grupo A, en donde están la Al y la A2a, y el grupo B, donde están B y la BI. De esas, la más presente es la A2a.
-¿En qué se diferencian?
-Las del grupo B son más cercanas a las secuencias chinas. Las del A probablemente pasaron por otras partes del mundo, más cerca de Europa. Si bien son diferentes en su genoma no se ha encontrado ninguna diferencia en la capacidad infectiva ni en el grado de severidad de la enfermedad. La variante A2a es también una de las más frecuente en todo el mundo. Esa se caracteriza por tener una mutación en la proteína Spike. Esa variante se originó probablemente después que el virus salió de Asia.
-¿Cómo están distribuidas estas mutaciones en Chile?
-Están bien distribuidas por todos lados, porque al comienzo la gente viajó a distintas regiones. No hay una variante que se restringa a un solo lugar. De las muestras que tenemos se puede concluir hasta ahora que tenemos secuencias más parecidas a las europeas.
Fernando Valiente, académico del Programa de Virología de la Universidad de Chile, aplaude esta plataforma. "Me parece maravilloso tener este mapa. Permite mantener una vigilancia constante de las variantes del virus que circulan Chile y eso nos permite conocer la evolución del virus, cuál es el origen. Eso, a su vez, repercute en ver cuáles son las características, si va cambiando en el tiempo en las diferentes poblaciones que va infectando. Eso es importante porque si va cambiando, puede repercutir en los métodos de diagnóstico que estamos utilizando. Nosotros tenemos un método de diagnóstico molecular que se basa en la secuencia genómica del virus y si este cambia, lo más seguro es que tengamos que precisar las sondas que se utilizan para hacer el diagnóstico. Sabemos a priori que la tendencia mundial dice que no cambia mucho y por lo mismo no se puede hablar de distintas cepas, sino de variantes".